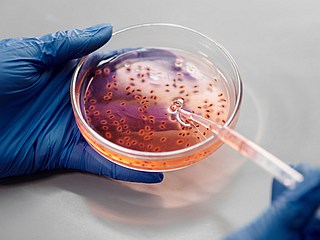
Bacteria Change Swimming Pattern While Navigating Through Tight Spaces: Researchers

- Home
- Science
- Science News
- New Patch Device Uses Electricity To Combat Harmful Skin Bacteria
New Patch Device Uses Electricity To Combat Harmful Skin Bacteria
A new device zaps harmful skin bacteria with electricity, potentially preventing infections.

Photo Credit: Saehyun Kim, the University of Chicago
The device targets harmful skin bacteria linked to bloodstream infections.
Scientists have developed a patch capable of tackling bacteria on the skin using mild electric pulses, which could help reduce infections if the bacteria were to enter the bloodstream. Known as the Bioelectronic Localized Antimicrobial Stimulation Therapy (BLAST) patch, this device emits a harmless electrical current designed to target specific skin bacteria that pose infection risks.
Testing Yields Promising Results on Pig Skin
The device was recently tested on pig skin, which shares structural similarities with human skin and is often used in preclinical studies. Researchers applied Staphylococcus epidermidis bacteria to the skin, which usually resides on human skin without causing harm. However, when these bacteria are introduced into the body via medical devices like catheters, they can lead to severe infections.
When placed on the pig skin, the BLAST patch released electric pulses every ten minutes over an 18-hour period, delivering a mild charge comparable to that used in pacemakers. This method significantly reduced the formation of biofilms—dense layers that help bacteria cling to surfaces and evade treatments—resulting in a nearly tenfold decrease in bacterial levels on the treated skin.
Mechanism Targets Bacteria in Specific Conditions
In laboratory tests, S. epidermidis showed a response to electrical currents only when the skin environment was mildly acidic, similar to human skin's natural pH. Researchers enhanced this effect by adding an acidifying hydrogel to the BLAST patch. Acidity is critical to suppressing bacterial biofilm development, complicating infection control in medical settings.
Early Findings Hint at Medical Applications
Published on 24 October in the journal Device, the BLAST patch might also be effective in sterilising surfaces of medical devices, providing an added layer of protection against bacterial infections. Bozhi Tian, one of the study's authors and a professor of chemistry at the University of Chicago, noted that reducing reliance on preventive antibiotics could help address antibiotic resistance concerns.
Further Testing Needed
Future research will explore BLAST's effectiveness on other bacterial strains and in animal and, eventually human trials. If proven successful, the device may offer a practical tool for infection prevention in medical facilities within five years.
Get your daily dose of tech news, reviews, and insights, in under 80 characters on Gadgets 360 Turbo. Connect with fellow tech lovers on our Forum. Follow us on X, Facebook, WhatsApp, Threads and Google News for instant updates. Catch all the action on our YouTube channel.
Related Stories
- Samsung Galaxy S26 Ultra
- Motorola Razr Fold
- ChatGPT
- OPPO Find N6
- Mobiles Under Rs. 40,000
- Vivo X300 Ultra
- Asus Zenbook S14
- iQOO 15
- Vivo X300 Pro
- Lenovo Yoga Slim 7i Aura Edition
- iQOO 15R
- Vivo X Fold 5
- Sony PlayStation 5
- HP OmniPad 12
- OnePlus Nord CE 6 Lite
- OnePlus Pad 4
- OPPO F33 Pro 5G
- Cryptocurrency
- HP OmniBook Ultra 14 (2026)
- iPhone 17
- Eureka Forbes AP 355 Room Air Purifier
- Latest Mobile Phones
- Compare Phones
- iQOO Z11i
- Samsung Galaxy Jump 5
- OPPO Reno 16c
- Redmi K90 Ultra
- OnePlus N6
- Samsung Galaxy M47 5G
- Vivo X Fold 6
- Vivo Y6a
- Asus Vivobook 15 (X1504MA)
- HP HyperX Omen 16 Valorant Limited Edition
- Red Magic Gaming Tablet 5 Pro
- Vivo Pad 5c
- Amazfit Cheetah 2 Ultra
- Amazfit Bip Max
- Sony Bravia 9 II
- Haier HQLED P7 Pro
- Acer Predator Atlas 8
- Asus ROG Ally
- IFB 1.5 Ton 3 Star Inverter Split AC (CI193GN22RGM3)
- IFB 2 Ton 3 Star Inverter Split AC (CI223GD32RGM3)